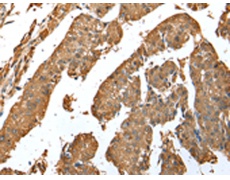
一抗

中文名稱: 兔抗ASB9多克隆抗體
|
Background: |
This gene encodes a member of the ankyrin repeat and suppressor of cytokine signaling (SOCS) box protein family. Members of this family can interact with the elongin B-C adapter complex via their SOCS box domain and further complex with the cullin and ring box proteins to form E3 ubiquitin ligase complexes. They may function to mediate the substrate-recognition of the E3 ubiquitin ligases. A transcribed pseudogene of this gene has been identified on chromosome 15. Multiple transcript variants encoding different isoforms have been found for this gene. |
|
Applications: |
ELISA, WB, IHC |
|
Name of antibody: |
ASB9 |
|
Immunogen: |
Full length fusion protein |
|
Full name: |
ankyrin repeat and SOCS box containing 9 |
|
SwissProt: |
Q96DX5 |
|
ELISA Recommended dilution: |
5000-10000 |
|
IHC positive control: |
Human liver cancer |
|
IHC Recommend dilution: |
25-100 |
|
WB Predicted band size: |
32 kDa |
|
WB Positive control: |
A549,A172 and Hepg2 cell |
|
WB Recommended dilution: |
200-1000 |


 購物車
購物車 幫助
幫助
 021-54845833/15800441009
021-54845833/15800441009